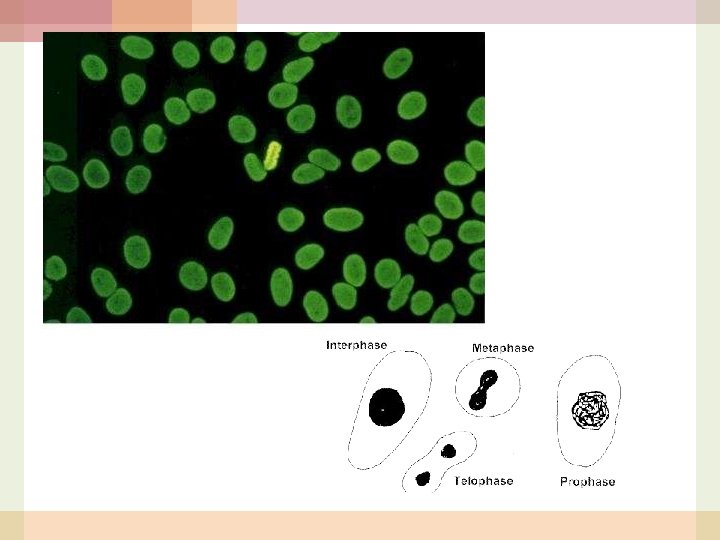
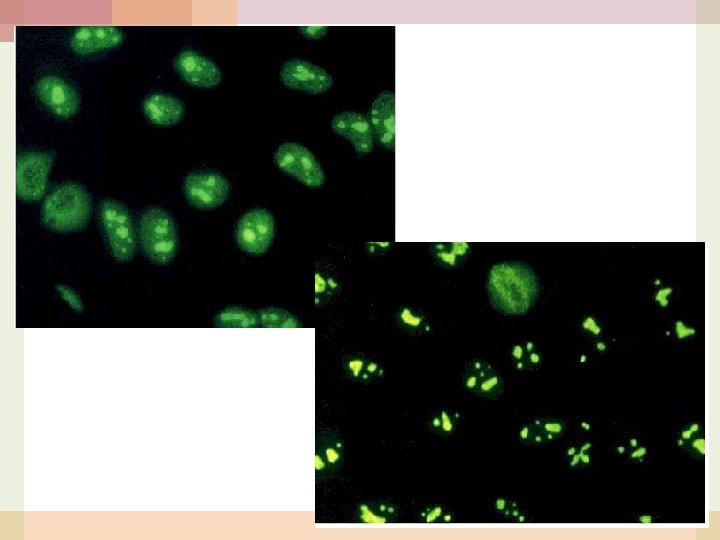

Rheumatoid Arthritis RA RF Ig G Fc portion

- Slides: 20
Rheumatoid Arthritis의 진단검 사 RA RF; Ig. G의 Fc portion 에 대한 Ig (m/c, Ig. M) 민감도 약 70% 특이도 약 70% preliminary criteria for Remission of RA Anti-CCP (anti-cyclic citrullinated peptide) Anti-perinuclear factor에 대한 Ab Antikeratin Ab 합쳐진 anti-filaggrin Ab 이들의 epitope이 citrulline 특이도가 90% 대로 향상
3. ANCA test • indirect IFL using neutrophils as substrate • p-ANCA • an artifact caused by the ethanol fixation of the neutrophils • which leads to the migration of some positively charged cytoplasmic antigens to the negatively charged nuclear envelope • 포르말린 고정시 항원이 세포질에 고정되어 c-ANCA pattern으로 나타남 (p-ANCA임을 재확인하는 방법) • MPO (p-ANCA) vs PR-3 (c-ANCA) in ELISA
Etc ESR CRP HLA typing Cryoglobulin Complement
장기특이 자가면역 질환 Autoimmune hepatitis Type I; anti-smooth m. Ab (SMA) Type II; anti-liver-kidney-microsomal Ab PBC AMA; specific marker DDx with PSC
Test Target vs Methodology ANA, ANCA by IIF ENA EIA
1. Indirect Immuno. Fluorescent test (IIF) m/c used routine test for ANA simple & sensitive, detection of wide range of ANA various substrates 1) frozen tissue sections of animal (mouse, rat. . ) liver or kidney - 2) cultured cell lines both nuclear & cytoplasmic structures - easily recognized homogenous population without too much extracellular matrix non-synchronized culture i) considerable number of dividing cells ii) detection of Ab to cell-cycle related Ag (rarely expressed in tissue sections) : m/c HEp-2 (human larynx carcinoma) large nuclei & nucleoli
2. ENA (Extractable Nuclear Antigen)test 다양한 조직으로부터 추출할 수 있는 saline soluble macromolecule의 총칭 two stage testing: initial ANA screening -> confirmatory ENA test significance of any positive ENA test in absence of a positive ANA must be interpreted with caution
3. EIA
대표적인 두 검사법; MAST vs Immuno. Cap
MAST Multiple allergen simultaneous test 화학발광변역측정법 (chemiluminescence test) 한꺼번에 여러 개의 항체검사 Thread에 coating되어 있는 Allergen에 혈청내의 Ig. E (specific)가 결합, 이에 Antibody Reagent를 반응시킨 후 Photoreagent를 첨가하여 발광된 정도를 Lumenometer로 Reading한다.